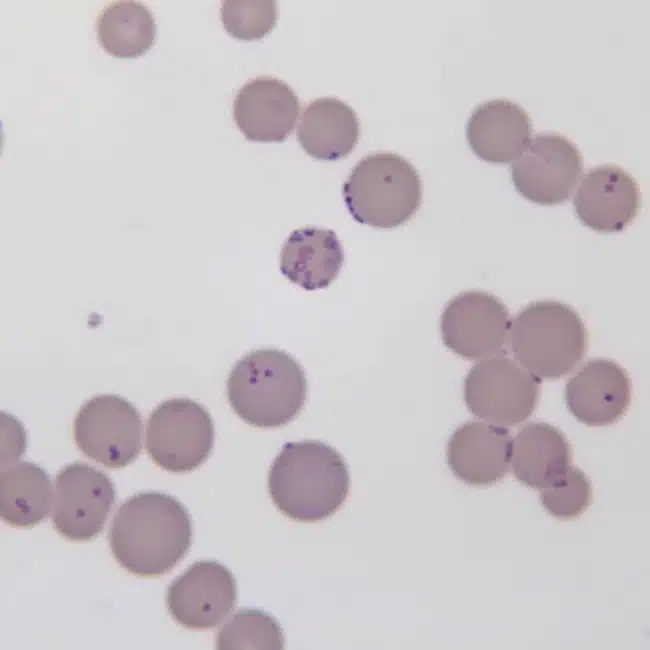

1. Tổng quan về nhiễm khuẩn Mycoplasma pneumoniae
Mycoplasma pneumoniae (MP) là vi khuẩn không có thành tế bào, thuộc họ Mycoplasmataceae. Đây là là căn nguyên phổ biến gây nhiễm trùng đường hô hấp ở con người, đặc biệt là trẻ em và thanh thiếu niên. Vi khuẩn này chủ yếu lây qua đường hô hấp, qua các giọt bắn từ người nhiễm bệnh khi ho, hắt hơi hoặc nói chuyện. Thời gian ủ bệnh thường kéo dài từ 1 đến 4 tuần, thường dẫn đến các triệu chứng hô hấp kéo dài nếu không được điều trị kịp thời 1.
Ở trẻ em, MP là nguyên nhân hàng đầu gây viêm phổi cộng đồng (community-acquired pneumonia – CAP), chiếm khoảng 20-40% các trường hợp CAP ở trẻ từ 5 tuổi trở lên, và lên đến 50% trong các đợt dịch. Triệu chứng điển hình bao gồm ho khan dai dẳng, sốt, đau đầu, mệt mỏi, đau họng và đôi khi là triệu chứng ngoài phổi như phát ban, viêm khớp, viêm màng não hoặc rối loạn tim mạch. Trong các trường hợp nặng, MP có thể gây viêm phổi nặng, hội chứng Stevens-Johnson, hoặc hội chứng Guillain-Barré. Trẻ em dưới 5 tuổi thường có triệu chứng nhẹ hơn, nhưng tỷ lệ nhiễm trùng ở nhóm tuổi này đang tăng lên sau đại dịch COVID-19 1.
Biến chứng của nhiễm MP ở trẻ em bao gồm cả hô hấp và ngoài hô hấp. Viêm phổi nặng có thể dẫn đến suy hô hấp, cần thở máy hoặc ICU, với tỷ lệ ICU khoảng 2-5% ở trẻ nhiễm mycoplasma pneumoniae kháng macrolid (Macrolide-resistant Mycoplasma pneumoniae – MRMP). Biến chứng ngoài phổi chiếm 25-30%, bao gồm viêm màng não, viêm tim, phát ban (erythema multiforme), và rối loạn đông máu. Trong các đợt dịch gần đây, trẻ em có tỷ lệ biến chứng cao hơn do chậm trễ điều trị, đặc biệt ở MRMP 3. Nghiên cứu từ Nhật Bản 2025 cho thấy MRMP liên quan đến thời gian sốt kéo dài và tăng sử dụng corticosteroid. Tổng thể, MP không chỉ là bệnh nhẹ mà có thể gây gánh nặng kinh tế-xã hội lớn, với chi phí điều trị tăng 2-3 lần ở trường hợp kháng thuốc 4.
2. Thách thức trong điều trị Mycoplasma pneumoniae
Điều trị MP đối mặt với nhiều thách thức, chủ yếu do sự gia tăng kháng macrolid, lạm dụng kháng sinh và hạn chế lựa chọn ở trẻ em. Macrolid (như azithromycin) là thuốc đầu tay từ lâu do tính an toàn và hiệu quả chống MP, nhưng tỷ lệ kháng tăng vọt từ năm 2000, đặc biệt ở Đông Á. Nguyên nhân chính là đột biến điểm ở domain V của gen 23S rRNA (A2063G hoặc A2064G), làm giảm ái lực của macrolid với ribosom. Tỷ lệ MRMP ở Trung Quốc lên đến 90-95%, Nhật Bản 50-80%, Hàn Quốc 70-80%. Tỷ lệ này ở Mỹ và châu Âu chỉ 3-13% nhưng có xu hướng đang tăng sau COVID 5.
Thách thức lớn nhất là MRMP dẫn đến thất bại điều trị ban đầu, kéo dài thời gian sốt cũng như nằm viện, và tăng nguy cơ phải chuyển thuốc thay thế (OR=4.42). Ở trẻ em, điều này tăng gánh nặng bệnh tật, với tỷ lệ ICU tăng 5 lần và chi phí cao hơn do phải dùng glucocorticoid hoặc IVIG 6. Ngoài ra, chẩn đoán MRMP thường chậm trễ vì cần thực hiện xét nghiệm PCR và không phải lúc nào cũng sẵn có. Điều này dẫn đến lạm dụng macrolid và tăng kháng thuốc 6.
Lạm dụng kháng sinh là yếu tố làm tăng tỉ lệ các chủng MRMP trong đó các nghiên cứu chỉ ra mối tương quan giữa sử dụng macrolid cao ở Đông Á và tỷ lệ đề kháng. Một thách thức không nhỏ gặp phải trên trẻ em là tính an toàn của các thuốc thay thế. Tetracyclin có nguy cơ ảnh hưởng men răng ở trẻ dưới 8 tuổi trong khi quinolon có thể ảnh hưởng tới khớp và sụn của trẻ. Đồng thuận năm 2024 khuyến cáo cần cân nhắc lợi ích – nguy cơ trong điều kiện thiếu dữ liệu về tính an toàn dài hạn 1.
Bội nhiễm với virus (như RSV, influenza) hoặc vi khuẩn khác làm chẩn đoán và điều trị khó khăn hơn, với tỷ lệ bội nhiễm lên đến 30-50% ở trẻ MRMP. Cuối cùng, thiếu vaccin và hướng dẫn toàn cầu làm tăng thách thức, đặc biệt ở các nước đang phát triển 1.
3. Nguyên tắc điều trị và lựa chọn kháng sinh
Nguyên tắc điều trị MP ở trẻ em là sớm, phù hợp và giảm thiểu kháng thuốc. Macrolid vẫn là lựa chọn đầu tay cho MP, với azithromycin (10 mg/kg/ngày, 3-5 ngày) hoặc clarithromycin (15 mg/kg/ngày, chia 2 lần, 7-10 ngày). Nếu không đáp ứng sau 48-72 giờ (sốt kéo dài, xấu đi), có thể nghi MRMP và chuyển thuốc thứ hai7.
Đối với MRMP, tetracyclin và quinolon là lựa chọn chính, do MP vẫn nhạy cảm in vitro (MIC thấp). Tetracycline: Doxycyclin (4 mg/kg/ngày, chia 2 lần, 7-10 ngày) cho trẻ trên 8 tuổi; minocyclin tương tự. Các phân tích gộp cho thấy tetracyclin rút ngắn sốt nhanh hơn (OR=5.34-40.77), tăng hiệu quả (OR=8.80) 8.Quinolon: Levofloxacin (8-10 mg/kg/ngày, 7-14 ngày) cho trường hợp nặng, nhưng thường được kê off-label trên trẻ dưới 18 tuổi do nguy cơ trên khớp 8.
Bảng liều lượng 1:
Ở trường hợp nặng, có thể kết hợp glucocorticoid (methylprednisolone 1-2 mg/kg/ngày) để giảm viêm nếu có tình trạng tắc nghẽn hoặc sử dụng IVIG nếu có biến chứng trên miễn dịch 9.
4. Kết luận và đề xuất
Nhìn chung, MP là nguyên nhân phổ biến gây CAP ở trẻ trong đó MRMP đang trở thành một thách thức lớn. Điều trị thường dựa trên đồng thuận, ưu tiên macrolid nhưng có thể chuyển nhanh sang các thuốc khác nếu có đề kháng. Cần giảm lạm dụng kháng sinh, và cần có thêm các nghiên cứu an toàn về tetracyclin và quinolon ở trẻ nhỏ để có thêm bằng chứng cho các khuyến cáo và đồng thuận trong tương lai.
Tài liệu tham khảo:
1. Wang YS, Zhou YL, Bai GN, et al. Expert consensus on the diagnosis and treatment of macrolide-resistant Mycoplasma pneumoniae pneumonia in children. World J Pediatr. 2024;20(9):901-914.
2. Erica P. Mycoplasma pneumoniae Infections Among Children and Adolescents in California. California Department of Public Health. 2025. Link: https://www.cdph.ca.gov/Programs/OPA/Pages/CAHAN/Mycoplasma-pneumoniae-Infections-Among-Children-and-Adolescents-in-California-.aspx
3. Smith C, Ng K, Sih K, Mcalpine A, Goldman RD. Resistant Mycoplasma pneumoniae in children. Can Fam Physician. 2025;71(7-8):487-489.
4. Oishi T, Kenri T, Yoshioka D. Macrolide-Resistant Mycoplasma pneumoniae Among Japanese Children from 2008 to 2024. Microorganisms. 2025; 13(10):2243.
5. Centrone, F., Accogli, M., Melilli, R. et al. Prevalence of Macrolide-Resistant Mycoplasma pneumoniae Infections After the COVID-19 Pandemic in Southern Italy, 2023–2025. Infect Dis Ther 14, 2733–2741 (2025).
6. Butpech T, Tovichien P. Mycoplasma pneumoniae pneumonia in children. World J Clin Cases 2025; 13(5): 99149.
7. Jesus GV. Mycoplasma pneumoniae infection in children. Uptodate: https://www.uptodate.com/contents/mycoplasma-pneumoniae-infection-in-children
8. Kang, D., Yun, K.W., Lee, T. et al. Treatment modalities for fever duration in children with Mycoplasma pneumoniae pneumonia. Sci Rep 15, 14860 (2025).
9. Subspecialty Group of Respiratory, the Society of Pediatrics, Chinese Medical Association; China National Clinical Research Center of Respiratory Diseases; Editorial Board, Chinese Journal of Pediatrics. Evidence-based guideline for the diagnosis and treatment of Mycoplasma pneumoniae pneumonia in children (2023). Pediatr Investig. 2025 Mar 11;9(1):1-11.
Biên tập: DS. Đỗ Khắc Huy, DS. Lê Thị Nguyệt Minh